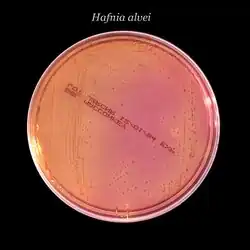

Hafnia
| Hafnia | |
|---|---|
![]() | |
| Classificação científica | |
| Reino: | Bactéria |
| Filo: | Proteobactéria |
| Classe: | Gama Proteobactéria |
| Ordem: | Enterobacteriales |
| Família: | Hafnia |
| Espécies: | Hafnia alvei |
Hafnia é um género de bactérias pertencentes à família das enterobactérias. O nome refere-se a Hafnia, nome latino de Copenhaga.
As Hafnia são bactérias da flora digestiva humana e animal, também presentes no meio-ambiente. Hafnia é frequentemente confundida com Salmonella cujas características bioquímicas são próximas, mas a ação lítica de bacteriófagos específicos permite distingui-los.
A principal espécie conhecida, Hafnia alvei, é uma bactéria característica do trato gastrointestinal humano e normalmente não-patogénica. É utilizada como fermento lático pela indústria láctea, e mais recentemente como probiótico (inclusive num produto de complemento alimentar para a regulação do apetite e perda de peso).
Histórico
O género Hafnia é um dos 40 géneros que compõem atualmente a família das Enterobactérias.
Embora descrita pelo biólogo dinamarquês Vagn Moller desde 1954 [1],a legitimidade deste grupo foi constantemente posta em causa ao longo das duas décadas seguintes, frequentemente designada por sinónimos tais como Enterobacter alvei, Enterobacter aerogenes subsp. hafniae e Enterobacter hafniae, mas a bactéria é sobretudo referenciada na literatura pelo nome atual, Hafnia alvei .[2]
Em 1977, um estudo concluiu que no fim do fabrico do “camembert”, a Hafnia alvei continua a ser a espécie dominante. Hafnia alvei é uma estirpe psicrotrófica, que pode desenvolver-se a temperatura baixa, o que significa que não pode desenvolver-se durante a fase de armazenamento do queijo, contrariamente à E. coli [3].
Em 1983, foi descoberta a família das Enterobactérias no “camembert” acabado de produzir [4]: 51% das Enterobactérias foram classificadas como sendo estirpes Hafnia alvei contra apenas 9% classificadas como Escherichia coli. Estes autores também demonstraram que a Hafnia alvei pode ser encontrada com uma concentração elevada no queijo (até 107 UFC/g), no leite cru e os queijos com base no leite pasteurizado.
Alguns anos mais tarde, em 1987, a Hafnia alvei foi identificada por uma equipa espanhola em leite cru de ovelha e representava 6,5% do total das Enterobacteriaceae.[5]
Em 1987, cientistas americanos que estudavam as Brassicaceae encontraram Hafnia alvei. Ao analisarem a microflora da couve frisada acabada de colher, pensaram que a origem da Hafnia alvei era uma contaminação do solo.[6]
Em 2004, cientistas mexicanos isolaram a Hafnia alvei (entre outras bactérias tais como a Lactobacillus acidophilus ou plantarum) de Pulque, uma bebida tradicional fabricada à base de maguei fermentada (também conhecida como agave).[7]
Em 2014, um estudo conjunto sobre a afinação do queijo, entre um laboratório do INRA e uma universidade italiana, identificou a H. alvei no leite cru utilizado no fabrico do queijo tradicional Caciocavallo Pugliese.[8]
A Hafnia alvei também se encontra nos alimentos fermentados, mesmo não sendo produtos lácteos. Nos últimos anos foi identificada em numerosos pratos tradicionais em todo o mundo.
Em 2014, a Hafnia alvei foi identificada no “aakhone”, um prato tradicional do norte da Índia à base de farinha de soja fermentada.[9]
A Hafnia também foi identificada nos grãos de café fermentados da Etiópia e no Ohio nos Estados Unidos [10]. Investigadores americanos estudaram o microbioma dos grãos de café e identificaram a Hafnia alvei entre outras numerosas estirpes e espécies, das quais 13 espécies de Enterobacteriales [11]. Este estudo sublinhou que a riqueza do microbioma dos grãos estava associada ao processo de fermentação, assim como à qualidade do café. A família de bactérias mais frequentemente identificada era a das Enterobacteriales que continham Hafnia alvei. Esta família é frequentemente encontrada em meios húmidos e ricos em elementos nutritivos semelhantes aos do café. Deste modo, esta bactéria poderia ter um papel essencial na fermentação.
A Hafnia alvei também foi identificada no kimchi comercial, uma refeição tradicional coreana à base de couve asiática, de rabanete, especiarias e marisco fermentado e salgado. Os cientistas sugerem que neste caso a origem da Hafnia é o marisco fermentado.[12]
Finalmente, a Hafnia alvei também foi isolada a partir de produtos com base em carne, especialmente carne de vaca refrigerada, devido à presença da Hafnia alvei nos bovinos abatidos. É possível identificá-la juntamente com E. Coli no chouriço (chorizo), uma salsicha espanhola semi-seca e fermentada.[7] A salsicha fermentada fabricada em Espanha também poderá conter a estirpe Hafnia alvei, responsável pela produção de histamina, essencial à maturação.[13]
Estirpe comensal
A maior parte dos textos de referência em microbiologia listam os mamíferos, os pássaros, os répteis, os peixes, o solo, a água, as águas residuais e os alimentos como fontes a partir das quais as bactérias Hafnia alvei podem ser recuperadas.
As vias gastrointestinais dos animais e em especial dos mamíferos, parecem ser um habitat ecológico muito comum para estas bactérias. Estudos de paleomicrobiologia permitiram a identificação da H. alvei proveniente de amostras de massa intestinal e de sedimentos recolhidos em restos de mamutes com 12 000 anos no Michigan e no Ohio. Num estudo que abrangeu 642 mamíferos australianos, Gordon e FitzGibbon [14] detetaram que a H. alvei era a terceira espécie entérica mais comumente identificada depois da Escherichia coli e da E. cloacae.
Também foram encontradas Hafniae esporadicamente nas amostras de dejetos de animais de grupo recolhidas nas áreas dos parques nacionais nos Estados Unidos e em 7% doe ursos Grizzli e ursos pretos testados.[15]
Entre as espécies avícolas, a H. alvei foi frequentemente isolada nas aves de rapina, incluindo falcões, mochos e o abutre indiano; mesmo na ferreirinha alpina de grande altitude que não têm praticamente qualquer contacto com os humanos, a Hafnia foi isolada em frequências de 3% a 16%.[16]
As outras fontes da H. alvei incluem os répteis (serpentes e escincidos), os invertebrados, os insetos, os peixes e os morcegos.
Papel na maturação do queijo
Conforme várias publicações, a Hafnia alvei encontra-se como espécie dominante durante a maturação do queijo de leite cru.[8][17]
A Hafnia alvei é uma bactéria psicrotrófica, originária do leite cru e continua a desenvolver-se nos queijos como o camembert. A multiplicação é um fator-chave no processo de fermentação e de maturação do queijo.
A estirpe Hafnia alvei está registada como micro-organismo utilizável na alimentação pela EFFCA (European Food & Feed Cultures Association).
Desde 1979, estudos sobre o queijo francês permitiram a identificação das correlações entre o desenvolvimento da Hafnia alvei e os parâmetros químicos aquando do fabrico do queijo. Vários investigadores consideraram que o nível de H. alvei atingia 107 CFU/g no fim do processo de maturação e mostraram que a curva de desenvolvimento estava estreitamente relacionada a um aumento do pH. Do mesmo modo, Mounier e al. mediram uma população em H. alvei de cerca de 109 CFU/g num modelo de queijo para barrar (queijo de pasta mole).[17]
Um estudo científico aprofundado dos queijos tradicionais consumidos há anos realça a presença de Hafnia alvei nos produtos lácteos desde há mais de trinta anos.
Concluindo, níveis abundantes de Hafnia alvei podem ser detetados no queijo de leite cru e têm um papel importante na aromatização do queijo devido do respetivo impacto na acidez e capacidade de produção de aminoácidos livres.
A Hafnia pode ser adicionada intencionalmente durante o processo de fabrico do queijo ou já existe como componente da microflora do leite. O microorganismo contribui para o processo de fermentação e também de maturação dos queijos. Estudos metabólicos revelaram que a bacteria é muito essencial para o processo de maturação e desenvolvimento do sabor típico do queijo.
Devido às suas propriedades que afetam a acidez e o sabor, a H. alvei é utilizada no fabrico de vários queijos, tais como o cheddar, o gouda e o camembert, assim como no Livarot e outros queijos de leite cru. A H. alvei também é comercializada na União Europeia como cultura de maturação para o “camembert” de aroma forte (Aroma-Prox AF 036, fornecido pela Bioprox SAS, França) ou como mistura de microrganismos para o aroma de queijo de pasta mole (Choozit Cheese cultures ARO 21 -HA LYO 10 D, fornecido pela Danisco, Dinamarca).
Um estudo levado a cabo em 2013 sobre o ecossistema de queijos modelo realçou o papel da Hafnia alvei na inibição do desenvolvimento da estirpe O26: H11 de E. coli sem modificação das concentrações de pH ou de ácido lático. Hafnia alvei produz uma pequena quantidade de amina biogénicas tais como a putrescina e a cadaverina, mas estas não afetaram o nível global dos compostos aromáticos voláteis.[18]
O interesse pelo papel da Hafnia alvei no fabrico do queijo continua a aumentar. Em 2007, um projeto da Agence Nationale de la Recherche (Agência Nacional de Investigação) (GRAMME) avaliou as vantagens e os riscos da Hafnia alvei na produção do queijo e estudou as outras funções potenciais para aumentar a respetiva aplicação a outros produtos alimentares.
Cultura
A hafnia desenvolve-se em meios com 2 a 5% de cloreto de sódio, uma gama de pH de 4,9 a 8,25 e gradientes térmicos de 4 a 44 °C [19]; a temperatura ótima para o desenvolvimento foi de 35 °C.[1]
Da opinião geral, quase 100 % das estirpes de hafnia desenvolvem-se em geloses MacConkey, Hektoen, eosina, azul de metileno e xilose-lisina-desoxicolato, que são todos eles meios seletivos a moderadamente seletivos.[19]
Nos meios seletivos mais inibidores, 25 a 60% das estirpes não se desenvolvem em gelose Salmonela-Shigela (SS), ao passo que 75 a 100% dos isolatos são inibidos num meio verde brilhante. As estirpes clássicas de H. alvei são lactose e sacarose negativas e como tais, surgem como colónias não nos meios de isolamento entérico.[2]
Nas geloses moderadamente seletivas, surgem em geral como colónias lisas de grandes dimensões, convexas e translúcidas de 2 a 3 mm de diâmetro com um bordo inteiro; algumas podem apresentar uma fronteira irregular.[2]
Biologia
Lipopolissacarídeos
A imunoquímica dos lipopolissacarídeos da Hafnia é extremamente complicada. Todos os lipopolissacarídeos da H. alvei parecem conter glucose, glucosamina, heptose e ácido 3-deoxioctulosónico. Alguns LPS contêm também outros amino-açúcares ou hidratos de carbono tais como manose, galactose, galactosamina e manosamina. A estrutura oligossacarídica de base de determinadas estirpes consiste numa estrutura hexassacarídica idêntica, composta por dois resíduos D-glucose, de três resíduos LD-heptose e um resíduo ácido 3-deoxioctulosónico. Existe uma grande diversidade serológica e imunológica neste género, e a investigação continua nesta área.[20]
Biotipos
Em 1969, Barbe descreveu dois biotipos de H. alvei com base na fermentação da arabinose D e salicina e na hidrólise de esculina e de arbutina. Um dos desafios que os microbiologistas enfrentam consiste em tentar desenvolver ensaios bioquímicos que permitissem distinguir facilmente a maioria das estirpes do grupo 1 (H. alvei sensu stricto) dos isolatos do grupo 2 (espécies não denominadas Hafnia). Estes dois grupos podem presentemente ser distinguidos uns dos outros através de uma série de testes. Não sendo qualquer dos testes totalmente discriminatório. No entanto, a mobilidade em 24 horas é presentemente o melhor indicador do grupo (grupo 1, 9% positivo, grupo 2, 100% positivo).[2]
Vantagens para a saúde
Hafnia produz uma proteína chamada Caseinolytic Protease B ( ClpB ), que demonstrou imitar o hormônio α-MSH que está envolvido na a sensação de saciedade.[21]
Ficou demonstrado que determinadas bactérias Enterobacteriacae, tais como a Hafnia alvei, regulam naturalmente o apetite.[22]
Em 2020, os resultados de um estudo clínico de 12 semanas que comparava a ingestão oral da estirpe HA45597 e um placebo [23], foram publicados durante o Virtual Congress on Clinical Nutrition and Metabolism (ESPEN). Este estudo prospetivo, multicêntrico, em dupla ocultação controlado por placebo e randomizado em 236 voluntários com excesso de peso (25 e 30 kg/m2) confirma clinicamente os dados pré-clínicos. Ambos braços seguiram um regime hipocalórico acompanhado quer pelo probiótico Hafnia alvei HA4597, quer por um placebo. O critério de avaliação principal relativo à perda de peso foi atingido: existe uma diferença estatística significativa a favor do probiótico na proporção de sujeitos que perderam pelo menos 3% do respetivo peso corporal no fim das 12 semanas. Entre os critérios secundários atingidos, um aumento estatisticamente significativo da sensação de saciedade. Por outro lado, o efeito do probiótico é também superior ao do placebo na redução do perímetro das ancas. Apenas o Hafnia alvei HA4597 surtiu efeito no nível de colesterol e induziu uma redução maior da glicemia do que a observada com o placebo. Finalmente, a estirpe Hafnia alvei HA4597 revelou-se como muito superior ao placebo através da avaliação global das vantagens identificadas tanto pelos médicos investigadores como pelos participantes.
A revista científica Nature qualificou recentemente a estirpe Hafnia alvei HA4597, como probiótico de precisão, isto é, um probiótico cuja estirpe e cujo mecanismo de ação estão perfeitamente descritos e compreendidos.[24]
TargEDys, a empresa francesa que demonstrou que a estirpe Hafnia alvei HA4597 podia estimular a saciedade através da proteína ClpB e ajudar a controlar naturalmente o apetite e a perda de peso, levou a cabo estudos que permitem a comercialização deste probiótico.
Patogenicidade e sensibilidade aos antimicrobianos
As informações sobre a patogenicidade da Hafnia alvei são limitadas. Embora este patogénico tenha sido encontrado em grande número nos excrementos, o líquido articular, o sangue e a urina apresentaram resultados negativos em cultura; o papel das hafniae na doença é discutível.[2]
Isto deve-se provavelmente à fraca ocorrência desta espécie nas doenças humanas e ao facto de não haver sintomas de doença bem definidos especificamente associados à H. alvei. As informações atuais relativas à patogenicidade da Hafnia podem ser examinadas de dois pontos de vista: os fatores de virulência potencialmente ativos nas infeções extraintestinais e os limitados principalmente aos intestinos. Um estudo menciona também que os ratos onde foram injetadas hafniae por via intraperitoneal não sucumbiram à infeção.[2]
A H. alvei é um patogénico humano raro apesar do aumento de atenção da comunidade médica ao longo da última década devido à respetiva associação possível à gastroenterite
Não há correlação clara entre os dados epidemiológicos, clínicos e de laboratório e um papel da Hafnia alvei nas patologias intestinais.
Num estudo que abrangeu 17 isolados de Hafnia alvei ("Enterobacter hafniae") recuperados pela Mayo Clinic de 1968 a 1970, apenas 5 isolados (29%) foram considerados clinicamente significativos. Em todos estes casos, a H. alvei foi identificada como sendo um patogénico secundário (respiratório: 2, abcesso: 3). No conjunto, a idade média das pessoas infetadas ou colonizadas por H. alvei era de 52,9 anos, com uma taxa de homens/mulheres de 1: 1,1.[25]
É interessante sublinhar que a American Type Culture Collection considera que todas as estirpes de Hafnia alvei pertencem ao nível de biossegurança 1 [26]. Além disso, Richard et coll. identificaram a presença de 108 de células viáveis por grama de queijo, o que sugere um consumo diário de mais de 109 de bactérias (cálculo baseado numa porção de 30 g) indicando o perfil correto de segurança da Hafnia alvei no consumo diário.
A segurança da Hafnia alvei nos pacientes imunocompetentes parece muito clara e foi demonstrada desde há mais de 4 décadas até ao presente.
Stock et coll. descrevem um estudo em 76 isolados de H. alvei, quanto à respetiva sensibilidade a 69 antibióticos ou medicamentos. O esquema geral que sobressai neste estudo é que esta bactéria é sensível aos carbapenemas, monobactamas, cloranfenicol, quinolonas, aminoglicosídeos e antifolatos (por exemplo trimetoprima-sulfametoxazol) e resistente à penicilina, à oxacilina e à amoxicilina associada ao ácido clavulânico. A sensibilidade às tetraciclinas e às cefalosporinas é variável.[27]
Um estudo espanhol, envolvendo patogénicos entéricos, também revelou que 32 estirpes de H. alvei eram universalmente sensíveis a todas as quinolonas (incluindo a gemifloxacina e a grepafloxacina), à cefotaxima, à gentamicina, ao cotrimoxazol e ao ácido naladíxico; 78% das estirpes deste estudo eram sensíveis à doxicilina. Algumas estirpes de H. alvei produzem simultaneamente cefalosporinases induzíveis de nível fraco (sensíveis à ceftazidima) e uma atividade de cefalosporinas constitutiva de nível elevado resistente à ceftazidima.
Um estudo clínico que testou a tomada da estirpe H. Alvei HA4597 num indivíduo com excesso de peso demonstrou a inocuidade perfeita deste probiótico.[25]
Estatuto regulamentar
Hafnia alvei é uma bactéria de qualidade alimentar. Não faz parte do catálogo Novel Food da Comissão europeia [28] mas faz parte da lista dinamarquesa das culturas microbianas autorizadas nos alimentos.[29]
A Hafnia alvei faz parte da lista publicada pela IDF (International Dairy Federation) das culturas alimentares microbianas que provam o nível de segurança muito bom desta estirpe nos produtos alimentares fermentados para utilização a nível mundial.[30]
A estirpe H alvei HA4597 é doravante comercializada em França como complemento alimentar associado ao Zinco e Crómio com a denominação EnteroSatys (TargEDys)[31] e Symbiosys Satylia (Biocodex[32]).
Referências
- 1 2 Møller, Vagn (1954). «Distribution of Amino Acid Decarboxylases in Enterobacteriaceae1». Acta Pathologica Microbiologica Scandinavica (em inglês) (3): 259–277. ISSN 1600-0463. doi:10.1111/j.1699-0463.1954.tb00869.x. Consultado em 16 de março de 2021
- 1 2 3 4 5 6 Janda, J. Michael; Abbott, Sharon L. (1 de janeiro de 2006). «The Genus Hafnia: from Soup to Nuts». Clinical Microbiology Reviews (em inglês) (1): 12–28. ISSN 0893-8512. PMID 16418520. doi:10.1128/CMR.19.1.12-28.2006. Consultado em 16 de março de 2021
- ↑ Mourgues, R.; Vassal, L.; Auclair, J.; Mocquot, G.; Vandeweghe, J. (1977). «Origine et développement des bactéries coliformes dans les fromages à pâte molle». Le Lait (em francês) (563-564): 131–149. ISSN 0023-7302. doi:10.1051/lait:1977563-5645. Consultado em 16 de março de 2021
- ↑ Richard, J.; Zadi, Halima (1983). «Inventaire de la flore bactérienne dominante des Camemberts fabriqués avec du lait cru». Le Lait (em francês) (623-624): 25–42. ISSN 0023-7302. doi:10.1051/lait:1983623-6243. Consultado em 16 de março de 2021
- ↑ Gaya, Pilar; Medina, Margarita; Nuntez, M. (1987). «Enterobacteriaceae, coliforms, faecal coliforms and salmonellas in raw ewes'milk». Journal of Applied Bacteriology (em inglês) (4): 321–326. ISSN 1365-2672. doi:10.1111/j.1365-2672.1987.tb04927.x. Consultado em 16 de março de 2021
- ↑ Senter, S. D.; Bailey, J. S.; Cox, N. A. (1987). «Aerobic Microflora of Commercially Harvested, Transported and Cryogenically Processed Col lards (Brassica oleracea)». Journal of Food Science (em inglês) (4): 1020–1021. ISSN 1750-3841. doi:10.1111/j.1365-2621.1987.tb14265.x. Consultado em 16 de março de 2021
- 1 2 Escalante, Adelfo; Elena Rodríguez, María; Martínez, Alfredo; López-Munguía, Agustín; Bolívar, Francisco; Gosset, Guillermo (1 de junho de 2004). «Characterization of bacterial diversity in Pulque, a traditional Mexican alcoholic fermented beverage, as determined by 16S rDNA analysis». FEMS Microbiology Letters (em inglês) (2): 273–279. ISSN 0378-1097. doi:10.1111/j.1574-6968.2004.tb09599.x. Consultado em 16 de março de 2021
- 1 2 Pasquale, Ilaria De; Cagno, Raffaella Di; Buchin, Solange; Angelis, Maria De; Gobbetti, Marco (1 de outubro de 2014). «Microbial Ecology Dynamics Reveal a Succession in the Core Microbiota Involved in the Ripening of Pasta Filata Caciocavallo Pugliese Cheese». Applied and Environmental Microbiology (em inglês) (19): 6243–6255. ISSN 0099-2240. PMID 25085486. doi:10.1128/AEM.02097-14. Consultado em 16 de março de 2021
- ↑ Deb, Chitta Ranjan; Jamir, Bendangnaro (30 de março de 2018). «Nutritional Assessment and Molecular Identification of Microorganisms from Akhuni/Axone: A Soybean Based Fermented Food of Nagaland, India». JOURNAL OF ADVANCES IN BIOLOGY (em inglês): 2170–2179. ISSN 2347-6893. doi:10.24297/jab.v11i1.7118. Consultado em 16 de março de 2021
- ↑ Tamang, J., Thapa, N., Tamang, B., Rai, A. & Chettri, R. Microorganisms in Fermented Foods and Beverages. 1–110 (2015).
- ↑ Vaughan, Michael Joe; Mitchell, Thomas; Gardener, Brian B. McSpadden (1 de outubro de 2015). «What's Inside That Seed We Brew? A New Approach To Mining the Coffee Microbiome». Applied and Environmental Microbiology (em inglês) (19): 6518–6527. ISSN 0099-2240. PMID 26162877. doi:10.1128/AEM.01933-15. Consultado em 16 de março de 2021
- ↑ Kim, Myunghee (2009). «Isolation of Hafnia Species from Kimchi». Journal of Microbiology and Biotechnology. ISSN 1017-7825. doi:10.4014/jmb.0807.416. Consultado em 16 de março de 2021
- ↑ Castaño, A; Garcı́a Fontán, M. C; Fresno, J. M; Tornadijo, M. E; Carballo, J (1 de março de 2002). «Survival of Enterobacteriaceae during processing of Chorizo de cebolla, a Spanish fermented sausage». Food Control. Food Safety Incentives in a Changing World Food System (em inglês) (2): 107–115. ISSN 0956-7135. doi:10.1016/S0956-7135(01)00089-5. Consultado em 16 de março de 2021
- ↑ Gordon, David M.; FitzGibbon, Frances (1999). «The distribution of enteric bacteria from Australian mammals: host and geographical effects». Microbiology, (10): 2663–2671. ISSN 1350-0872. doi:10.1099/00221287-145-10-2663. Consultado em 16 de março de 2021
- ↑ L. J. Goatcher, M. W. Barrett, R. N. Coleman, A. W. L. Hawley, A. A. Qureshi: . In: . Band 33, Nr. 11, 1. November 1987, ISSN 0008-4166, S. 949–954, doi:10.1139/m87-167.
- ↑ J. Timko, V. Kmeť: Susceptibility of Enterobacteriaceae from the Alpine Accentor Prunella collaris, in Acta Veterinaria Brno. Band 72, Nr. 2, 2003, ISSN 0001-7213, S. 285–288, doi:10.2754/avb200372020285
- 1 2 J. Mounier, C. Monnet e T. Vallaeys, Microbial Interactions within a Cheese Microbial Community, in Applied and Environmental Microbiology, vol. 74, n. 1, 2 novembre 2007, p. 172–181, DOI:10.1128/aem.01338-07
- ↑ C. Delbès-Paus, S. Miszczycha e S. Ganet, Behavior of Escherichia coli O26:H11 in the presence of Hafnia alvei in a model cheese ecosystem, in International Journal of Food Microbiology, vol. 160, n. 3, 2013-01, p. 212–218, DOI:10.1016/j.ijfoodmicro.2012.10.019
- 1 2 S. GREIPSSON e F. G. PRIEST, Numerical Taxonomy of Hafnia alvei, in International Journal of Systematic Bacteriology, vol. 33, n. 3, 1º luglio 1983, p. 470–475, DOI:10.1099/00207713-33-3-470
- ↑ Ewa Katzenellenbogen, Nina A. Kocharova e George V. Zatonsky, Structure of the O-polysaccharide of Hafnia alvei strain PCM 1189 that has hexa- to octasaccharide repeating units owing to incomplete glucosylation, in Carbohydrate Research, vol. 340, n. 2, 2005-02, p. 263–270, DOI:10.1016/j.carres.2004.11.009
- ↑ N Tennoune, P Chan e J Breton, Bacterial ClpB heat-shock protein, an antigen-mimetic of the anorexigenic peptide α-MSH, at the origin of eating disorders, in Translational Psychiatry, vol. 4, n. 10, 2014-10, p. e458–e458, DOI:10.1038/tp.2014.98
- ↑ Sergueï O. Fetissov, Role of the gut microbiota in host appetite control: bacterial growth to animal feeding behaviour, in Nature Reviews Endocrinology, vol. 13, n. 1, 12 settembre 2016, p. 11–25, DOI:10.1038/nrendo.2016.150
- ↑ Dechelotte P., Breton J., Trotin-Picolo C., Grube B., Erlenbeck C., Bothe G., Lambert G., The probiotic strain H. Alvei HA4597 improves weight loss in overweight subjects under moderate hypocaloric diet : a multicenter randomized, placebo-controlled study, Virtual Congress on Clinical Nutrition & Metabolism, September 19-20, 2020 DOI : 10.1016/j.clnesp.2020.09.762
- ↑ Patrick Veiga, Jotham Suez e Muriel Derrien, Moving from probiotics to precision probiotics, in Nature Microbiology, vol. 5, n. 7, 11 maggio 2020, p. 878–880, DOI:10.1038/s41564-020-0721-1
- 1 2 J. A. Washington, R. J. Birk e R. E. Ritts, Bacteriologic and Epidemiologic Characteristics of Enterobacter hafniae and Enterobacter liquefaciens, in Journal of Infectious Diseases, vol. 124, n. 4, 1º ottobre 1971, p. 379–386, DOI:10.1093/infdis/124.4.379
- ↑ Biosafety Level, su www.lgcstandards-atcc.org.
- ↑ Ingo Stock, Motiur Rahman e Kimberley Jane Sherwood, Natural antimicrobial susceptibility patterns and biochemical identification of Escherichia albertii and Hafnia alvei strains, in Diagnostic Microbiology and Infectious Disease, vol. 51, n. 3, 2005-03, p. 151–163, DOI:10.1016/j.diagmicrobio.2004.10.008
- ↑ Anonymous (17 de outubro de 2016). «Novel food catalogue». Food Safety - European Commission (em inglês). Consultado em 16 de março de 2021
- ↑ Inge Larsen, Charlotte Kristiane Hjulsager e Anders Holm, A randomised clinical trial on the efficacy of oxytetracycline dose through water medication of nursery pigs on diarrhoea, faecal shedding of Lawsonia intracellularis and average daily weight gain, in Preventive Veterinary Medicine, vol. 123, 2016-01, p. 52–59, DOI:10.1016/j.prevetmed.2015.12.004
- ↑ Salvatore Coppola, Giuseppe Blaiotta e Danilo Ercolini, Dairy Products, Molecular Techniques in the Microbial Ecology of Fermented Foods, Springer New York (ISBN 9780387745190, online ), p. 31–90
- ↑ https://www.targedys.com/fr/
- ↑ https://www.biocodex.fr/fr/